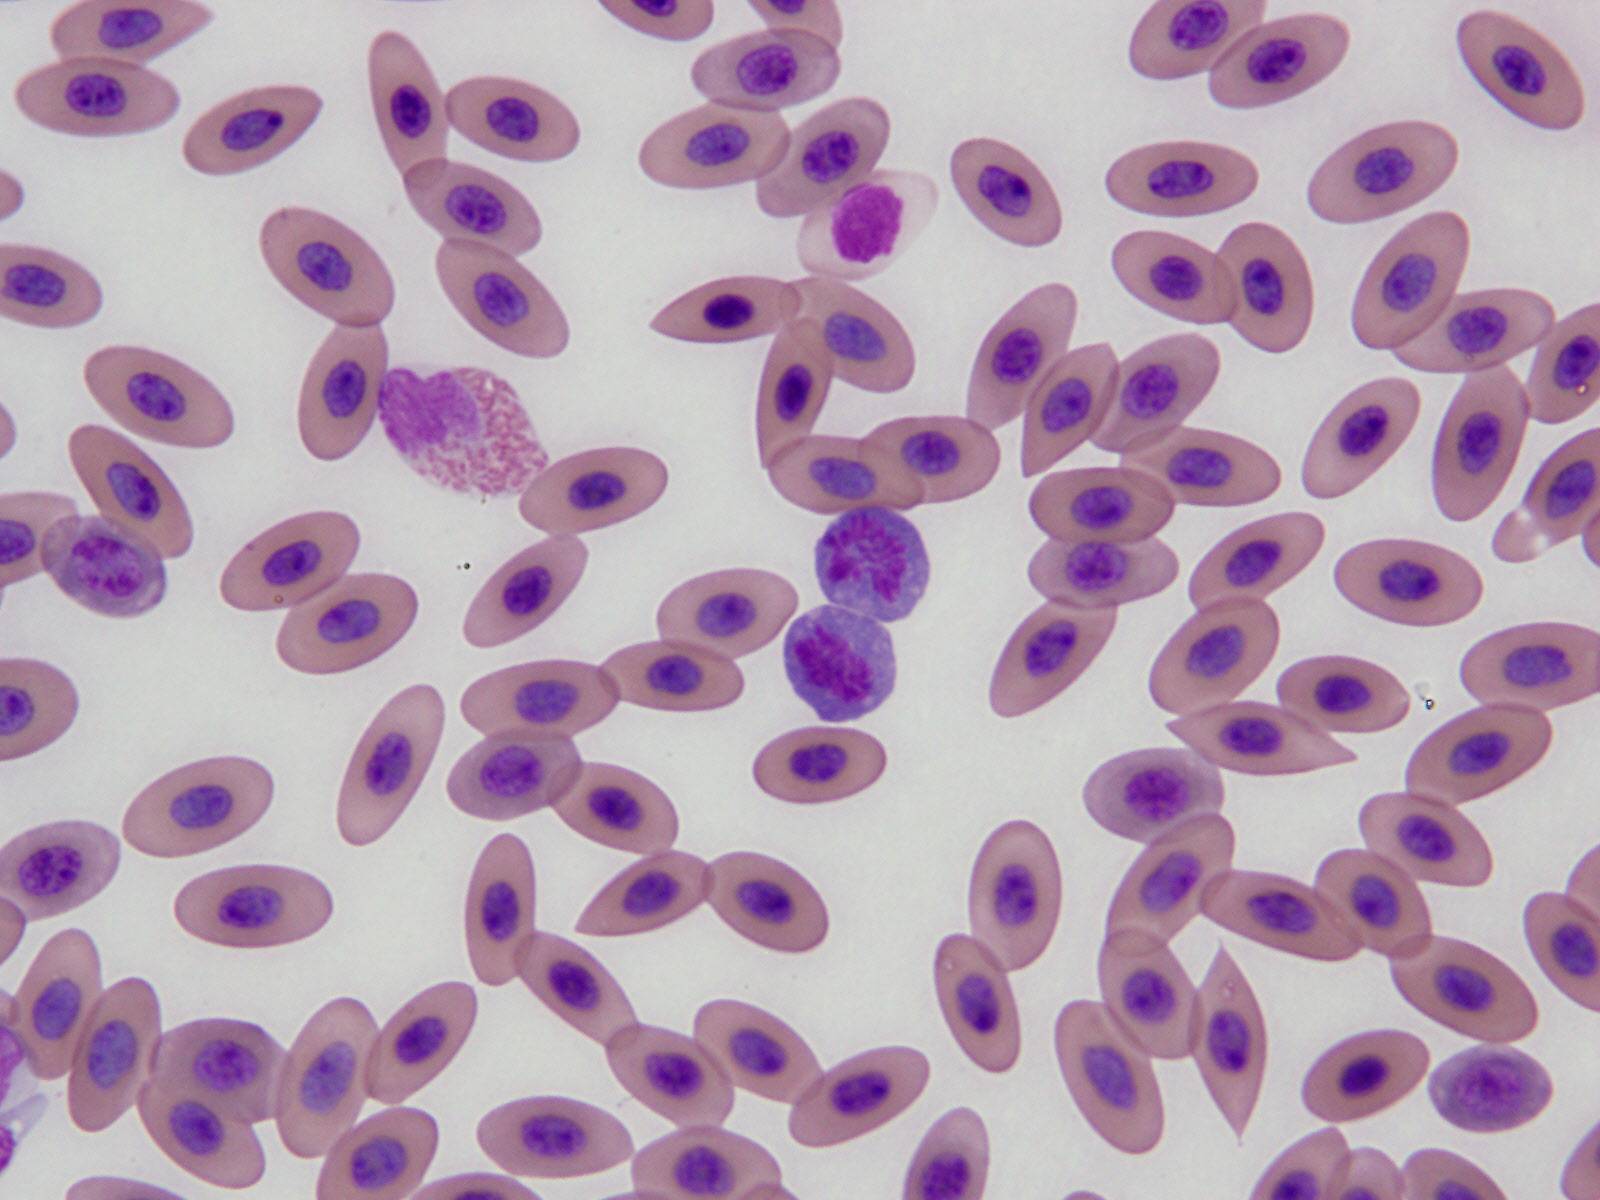
フンボルトペンギン血液塗抹.jpg
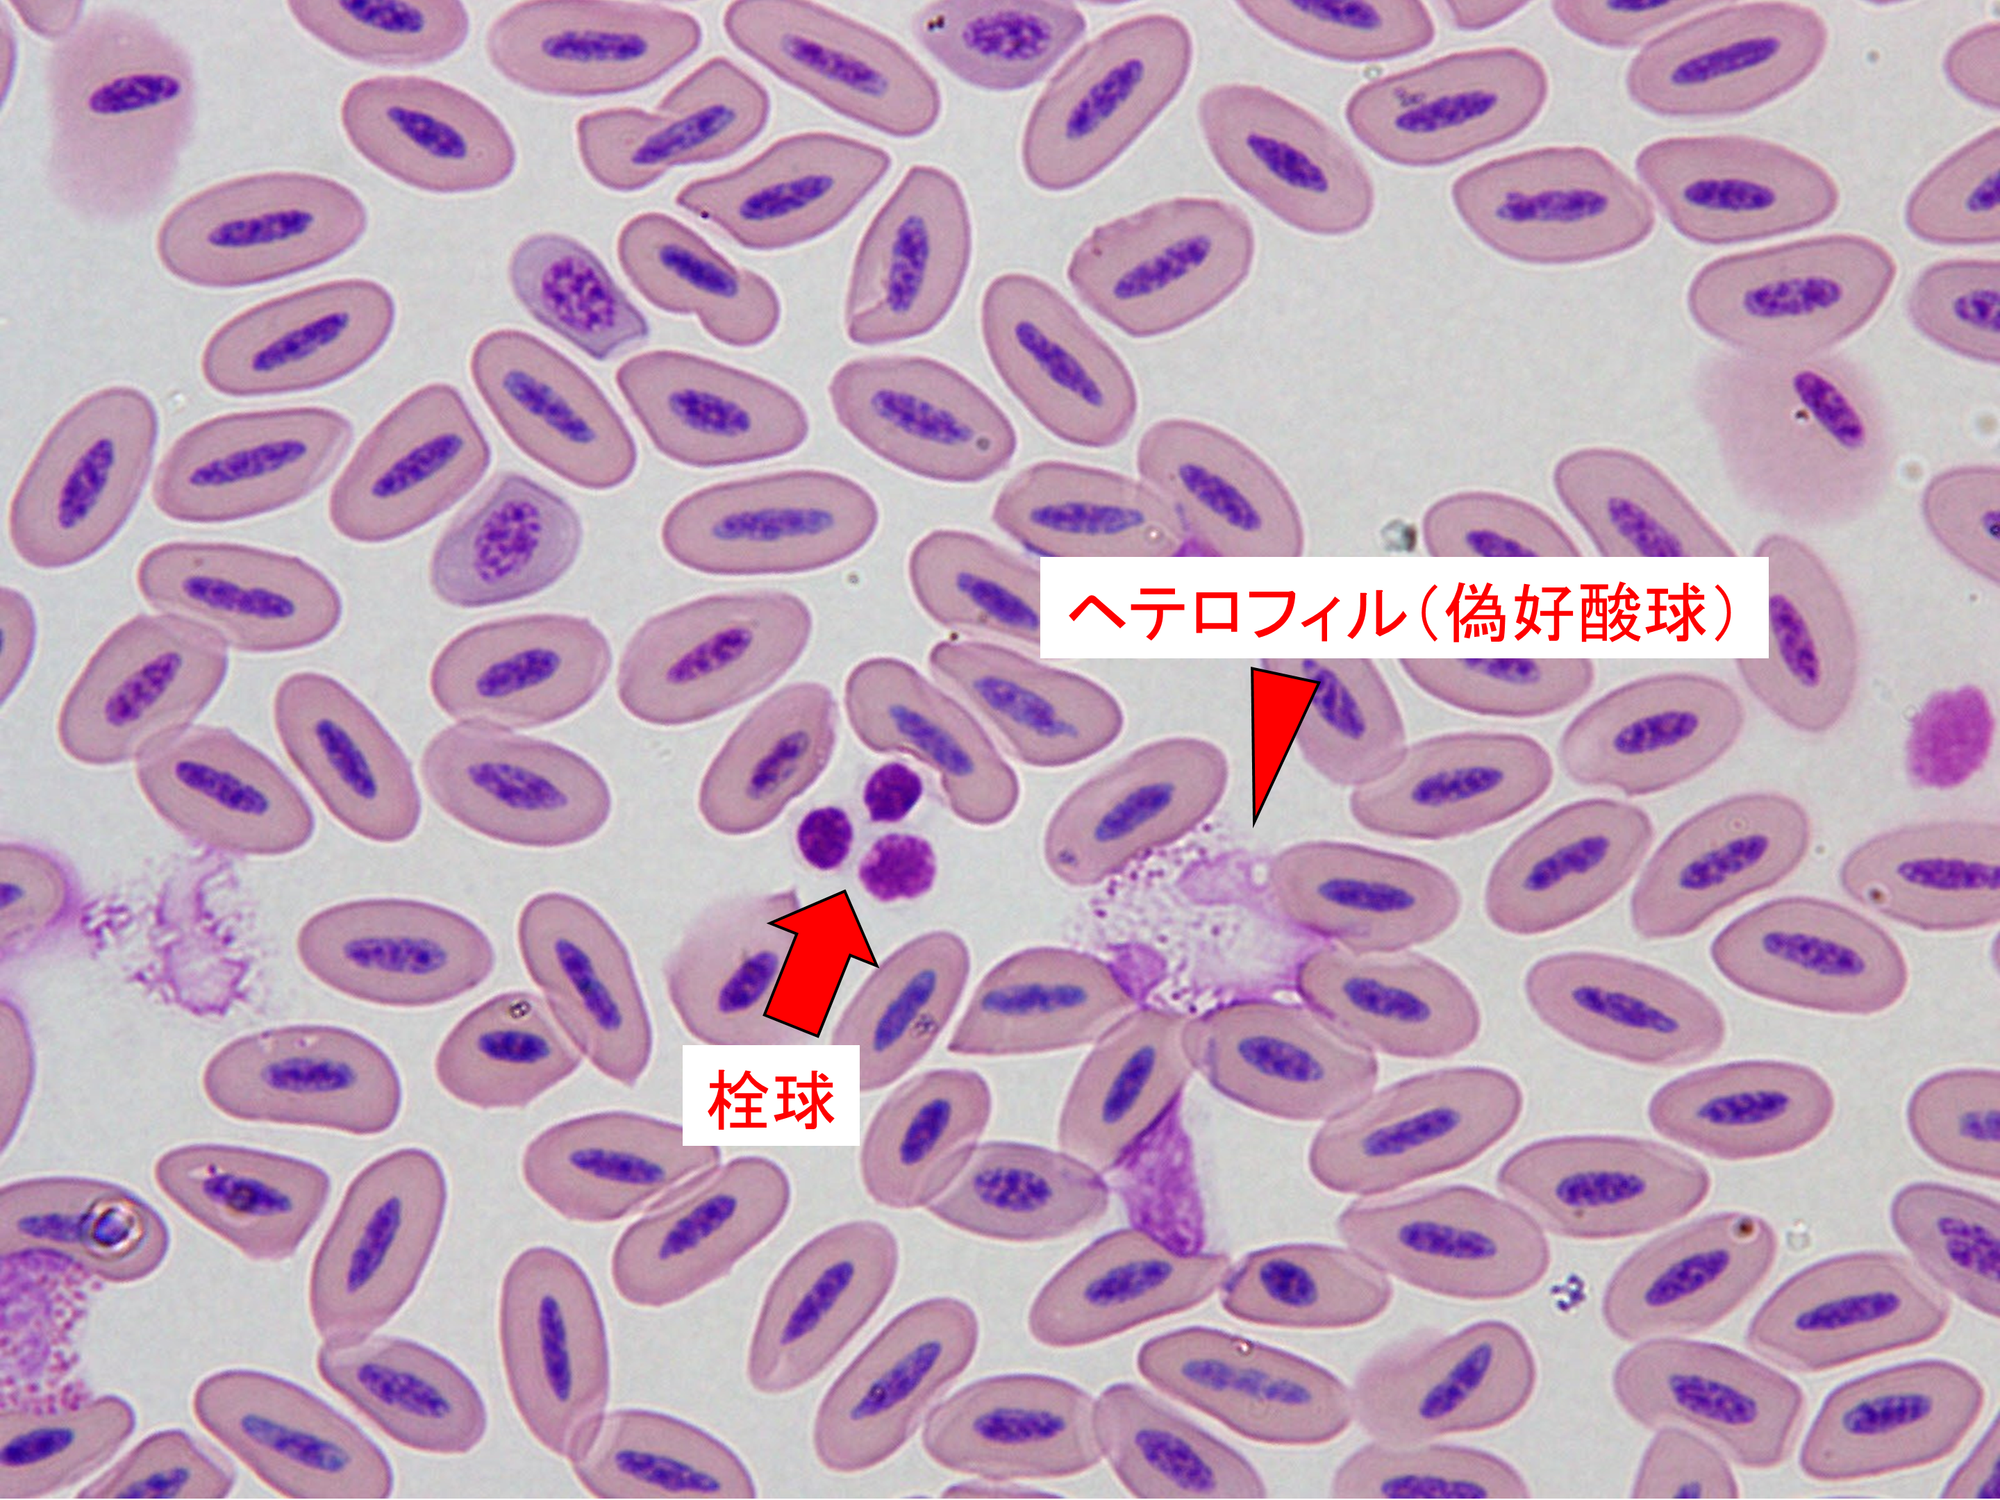
ミナミジサイチョウ血液塗抹.png

更新日:2026.02.07【獣医ブログ】血液の中ではたらく細胞①
【獣医ブログ】血液の中ではたらく細胞①
皆さんこんにちは!
病院担当です。
以前のブログで動物たちの「採血」についてご紹介しましたが、今回はその採血でとった「血液」についてご紹介したいと思います。
(以前のブログ:【獣医ブログ】あなたの血はどこから?①)
学校の授業などで学んだことがある方も多いかと思いますが、血液の中には様々な細胞(血球)が含まれています。
哺乳類の血球は、酸素を運ぶ役割を持つ「赤血球」、免疫反応などに関係する「白血球」、止血に関係する「血小板」の大きく3種類に分けられます。
さらに、白血球はリンパ球や好中球、好酸球などに細かく分類されます。
実はこれらの細胞、動物によって見た目や種類に違いがあります。
血液塗抹標本(血液をうすーくのばして、観察しやすいように染色したもの)を顕微鏡で観察した写真を使って、動物種ごとの違いを少しだけご紹介します。
まずは基本的な哺乳類の血球から。

アカカンガルーの血液塗抹標本です。
たくさん見える赤く染まった円形の細胞は「赤血球」です。
正常な赤血球は、真ん中がへこんだ円盤状の形をしています。
中央に見える赤血球より大きい細胞は「白血球」。
紫色のくびれた核を持つこの白血球は「分葉核好中球」と呼ばれ、白血球の中で最も多く見られます。
続いては、ヒトコブラクダの血液塗抹標本です。

カンガルーの血液との違いがお分かりいただけるでしょうか?
大きな違いは赤血球の形。
一般的な哺乳類の赤血球は円形ですが、ラクダやラマ、アルパカなどのラクダ科の赤血球は楕円形をしています。
この形のため、脱水時も血管の中を通過しやすいと考えられています。
さらに赤血球の膜の構造も他の哺乳類とは異なり、この赤血球の形態のおかげで脱水や大量の飲水に耐え、砂漠などの過酷な環境に適応していると考えられています。
続いてはこちら。
フンボルトペンギンの血液塗抹標本です。
ラクダと同じく楕円形の血球がたくさんありますが、ラクダとは異なり、紫色の核が存在します。
哺乳類の赤血球は成熟過程で核を失いますが、鳥類や爬虫類の赤血球には核が残ったままになっています(有核赤血球)。
また、鳥類や爬虫類では、赤血球以外の血球においても哺乳類との違いがあります。
例えば、哺乳類の血小板にあたる血球は「栓球」と呼ばれます。
血小板は核を持ちませんが、栓球は核を持っています。
また、哺乳類の白血球の中で最もよく見られる好中球ですが、鳥類や爬虫類では染色性の違いから「ヘテロフィル(偽好酸球)」と呼ばれます。
こちらはミナミジサイチョウの血液塗抹標本です。
いかがでしたか?
私たち獣医師は、動物たちから採取した血液を用いて検査を行い、見た目では分からない様々な情報を得ます。
次回は、実際に血液塗抹から分かる動物の病気をご紹介します!
お楽しみに~!
☆病院班☆